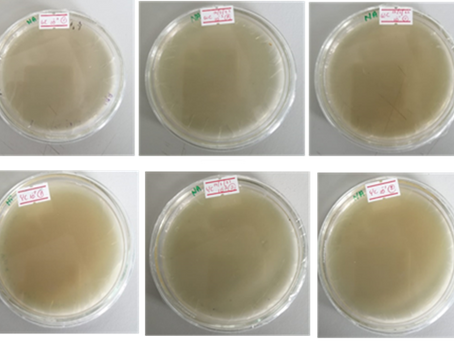
Evaluation of formulated Clay face mask

top of page


Formulation and Evaluation of Kaolin-Clay-based Face Mask
About Me
I am a Bachelor of Biosystems Technology (Hons) graduate focused on
Industrial Biotechnology at the University of Sri Jayewardenepura Sri Lanka
I am passionate about Cosmetics and cosmetic formulations

bottom of page
.png)